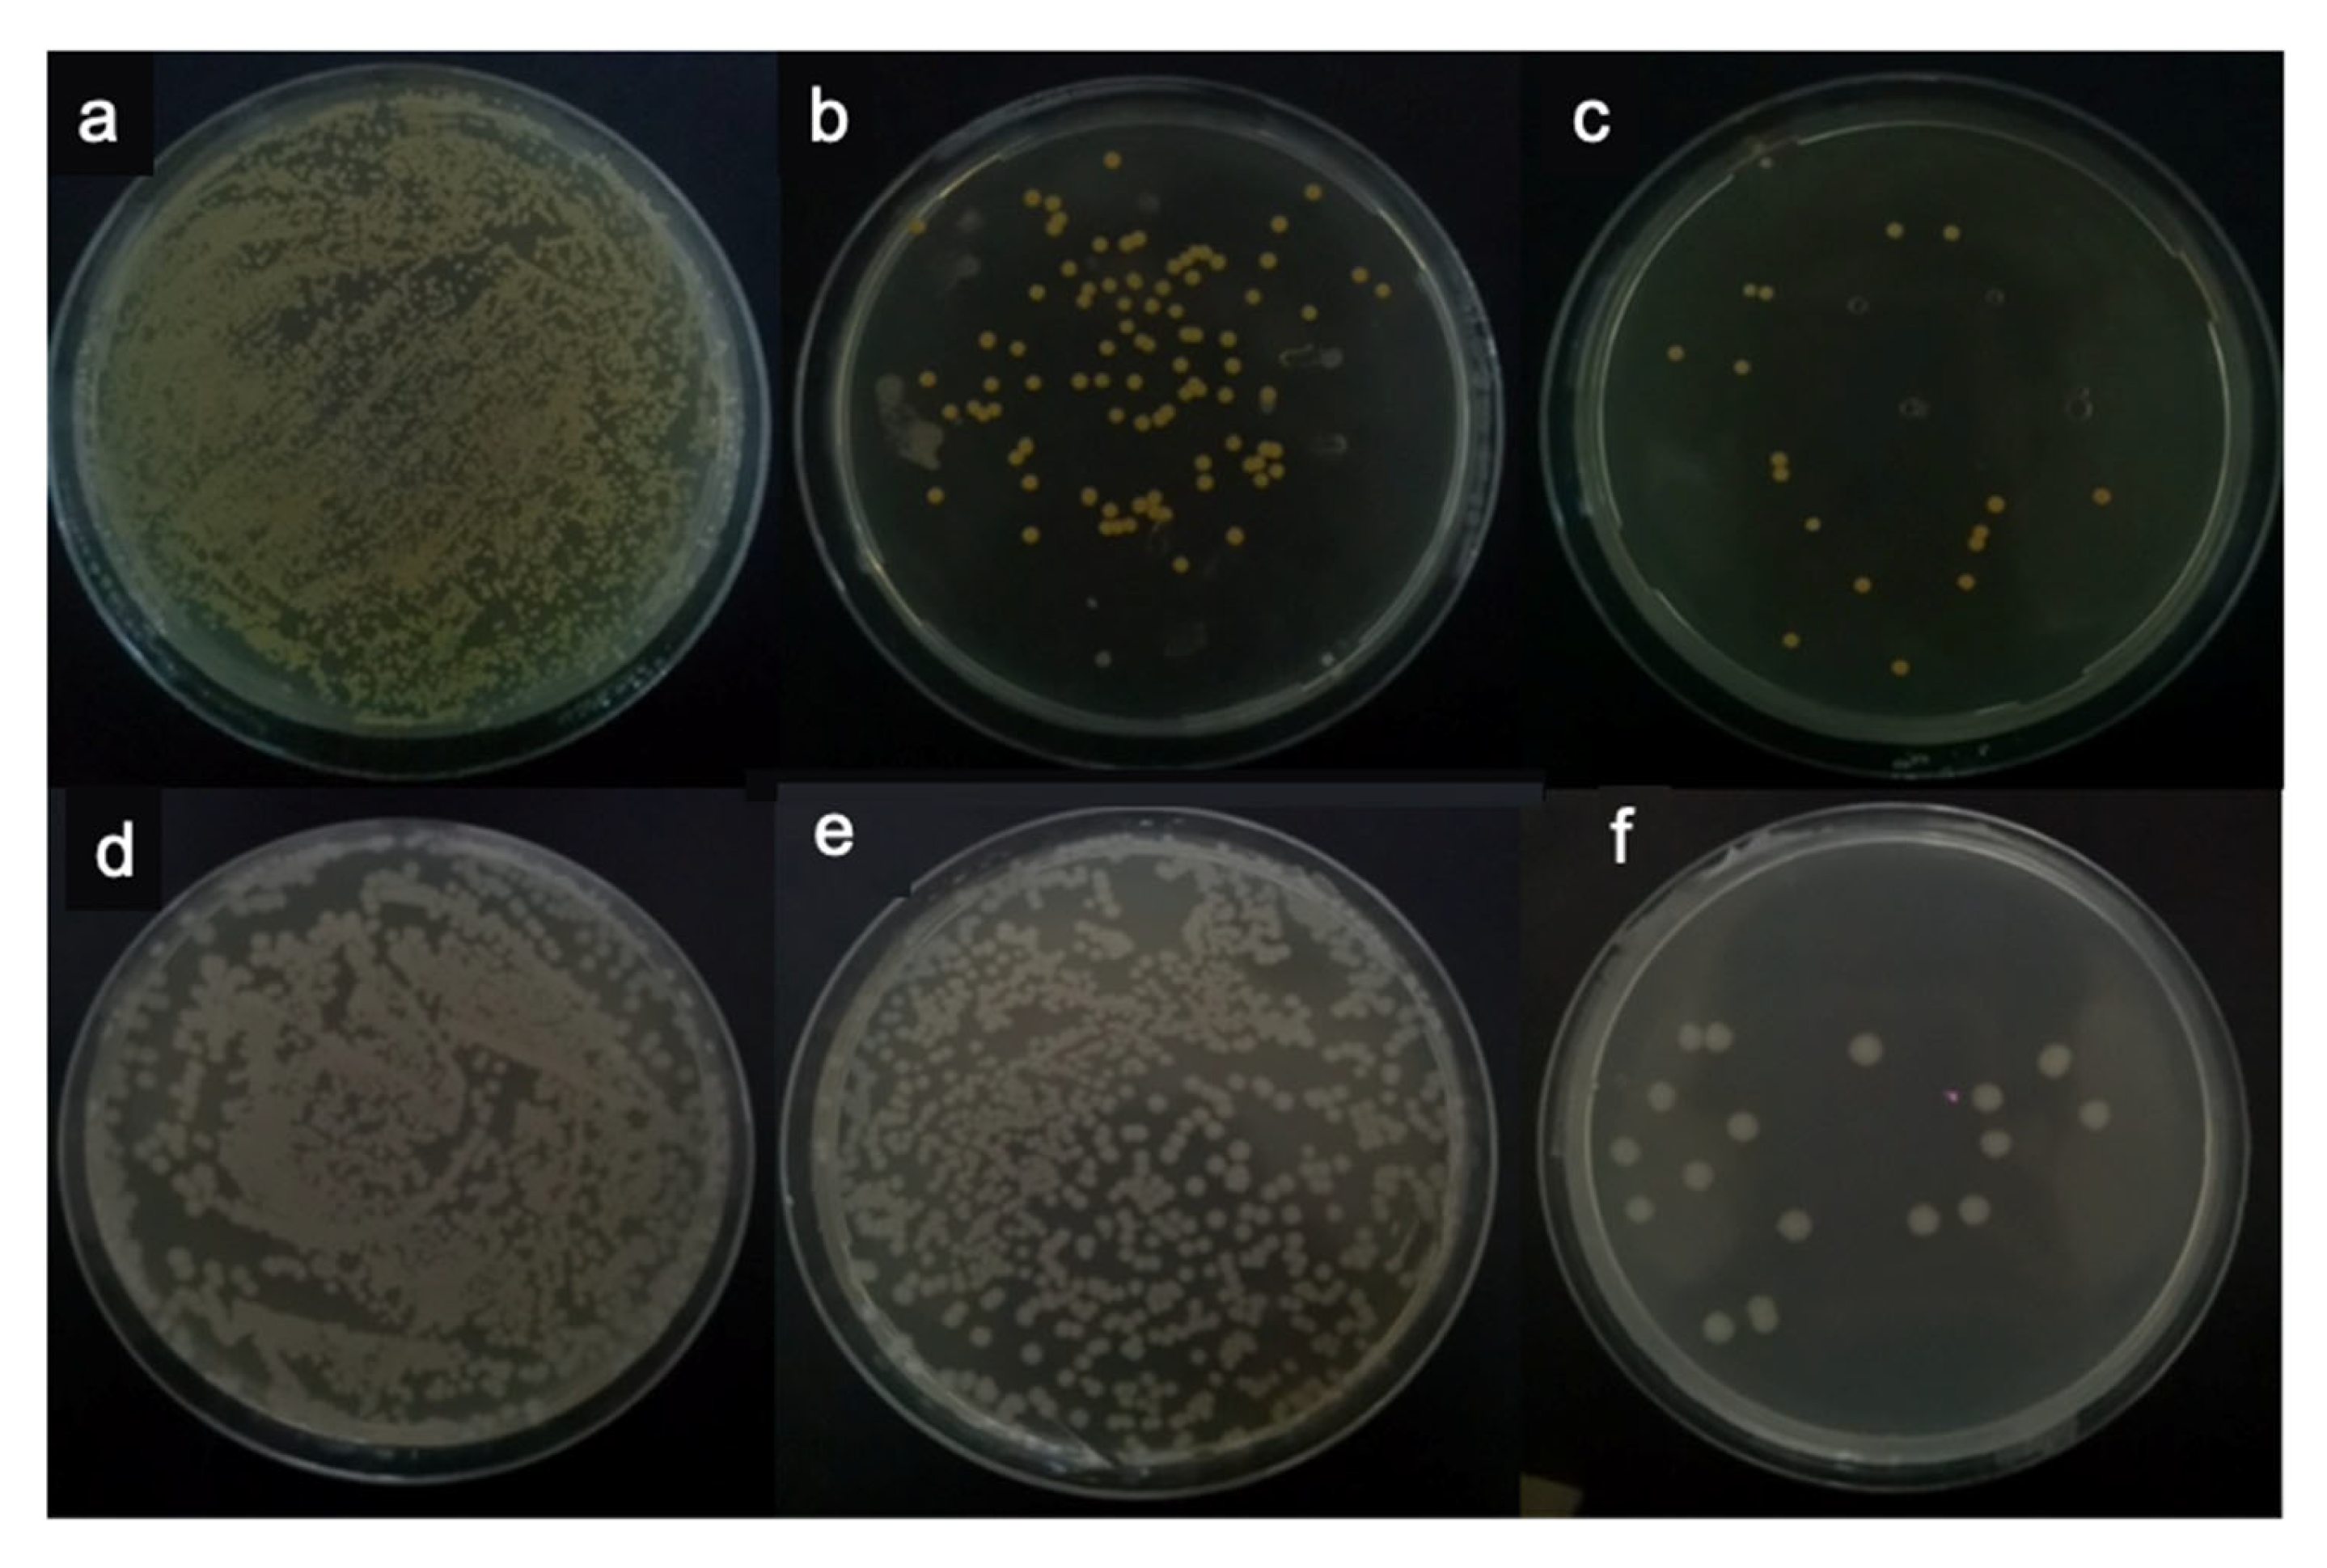
Materials 14 06901 g006

Mussel-Inspired Carboxymethyl Chitosan Hydrogel Coating of Titanium Alloy with Antibacterial and Bioactive Properties
Abstract
:1. Introduction
2. Materials and Methods
2.1. Materials
2.2. Preparation of CMCS-GA
2.3. Preparation of CMCS-GA Hydrogel on Titanium Alloy Plate
2.4. Fourier-Transform Infrared (FTIR) Spectroscopy
2.5. Scanning Electron Microscope (SEM)
2.6. Water Contact Angle
2.7. X-ray Photoelectron Spectroscopy (XPS)
2.8. Antibacterial Property
2.9. Cell Viability
3. Results and Discussion
3.1. FTIR Test
3.2. Surface Morphology
3.3. Water Contact Angle
3.4. Chemical Composition
3.5. Antibacterial Activity
3.6. Cell Viability
4. Conclusions
Author Contributions
Funding
Institutional Review Board Statement
Informed Consent Statement
Data Availability Statement
Conflicts of Interest
References
- Hanawa, T. A comprehensive review of techniques for biofunctionalization of titanium. J. Periodontal Implant. Sci. 2011, 41, 263–272. [Google Scholar] [CrossRef] [PubMed] [Green Version]
- Cui, C.; Hu, B.; Zhao, L.; Liu, S. Titanium alloy production technology, market prospects and industry development. Mater. Des. 2011, 32, 1684–1691. [Google Scholar] [CrossRef]
- McManamon, C.; de Silva, J.P.; Delaney, P.; Morris, M.A.; Cross, G.L. Characteristics, interactions and coating adherence of heterogeneous polymer/drug coatings for biomedical devices. Mater. Sci. Eng. C 2016, 59, 102–108. [Google Scholar] [CrossRef]
- Cheng, H.; Yue, K.; Kazemzadeh-Narbat, M.; Liu, Y.; Khalilpour, A.; Li, B.; Zhang, Y.S.; Annabi, N.; Khademhosseini, A. Mussel-Inspired Multifunctional Hydrogel Coating for Prevention of Infections and Enhanced Osteogenesis. ACS Appl. Mater. Interfaces 2017, 9, 11428–11439. [Google Scholar] [CrossRef] [PubMed] [Green Version]
- Le Thi, P.; Lee, Y.; Thi, T.T.H.; Park, K.M.; Park, K.D. Catechol-rich gelatin hydrogels in situ hybridizations with silver nanoparticle for enhanced antibacterial activity. Mater. Sci. Eng. C 2018, 92, 52–60. [Google Scholar] [CrossRef]
- Ryu, J.H.; Lee, Y.; Kong, W.H.; Kim, T.G.; Park, T.G.; Lee, H. Catechol-Functionalized Chitosan/Pluronic Hydrogels for Tissue Adhesives and Hemostatic Materials. Biomacromolecules 2011, 12, 2653–2659. [Google Scholar] [CrossRef]
- Chen, S.; Yuan, L.; Li, Q.; Li, J.; Zhu, X.; Jiang, Y.; Sha, O.; Yang, X.; Xin, J.H.; Wang, J.; et al. Durable Antibacterial and Nonfouling Cotton Textiles with Enhanced Comfort via Zwitterionic Sulfopropylbetaine Coating. Small 2016, 12, 3516–3521. [Google Scholar] [CrossRef]
- Porto, C.L.; Palumbo, F.; Buxadera-Palomero, J.; Canal, C.; Jelinek, P.; Zajickova, L.; Favia, P. On the plasma deposition of vancomycin-containing nano-capsules for drug-delivery applications. Plasma Process. Polym. 2018, 15, 1700232. [Google Scholar] [CrossRef]
- Qi, H.; Shan, P.; Wang, Y.; Li, P.; Wang, K.; Yang, L. Nanomedicines for the Efficient Treatment of Intracellular Bacteria: The “ART” Principle. Front. Chem. 2021, 9, 924. [Google Scholar] [CrossRef]
- Qi, H.; Yang, L.; Shan, P.; Zhu, S.; Ding, H.; Xue, S.; Wang, Y.; Yuan, X.; Li, P. The Stability Maintenance of Protein Drugs in Organic Coatings Based on Nanogels. Pharmaceutics 2020, 12, 115. [Google Scholar] [CrossRef] [Green Version]
- Lei, S.; Yan-Feng, X.; Lu, G.; Yao, W.; Fang, W.; Zhong-Wei, G. The effect of antibacterial ingredients and coating microstructure on the antibacterial properties of plasma sprayed hydroxyapatite coatings. Surf. Coat. Technol. 2012, 206, 2986–2990. [Google Scholar] [CrossRef]
- Jia, Z.; Xiu, P.; Li, M.; Xu, X.; Shi, Y.; Cheng, Y.; Wei, S.; Zheng, Y.; Xi, T.; Cai, H.; et al. Bioinspired anchoring AgNPs onto micro-nanoporous TiO2 orthopedic coatings: Trap-killing of bacteria, surface-regulated osteoblast functions and host responses. Biomaterials 2015, 75, 203–222. [Google Scholar] [CrossRef]
- Abramenko, N.B.; Demidova, T.B.; Abkhalimov, V.; Ershov, B.G.; Krysanov, E.Y.; Kustov, L.M. Ecotoxicity of different-shaped silver nanoparticles: Case of zebrafish embryos. J. Hazard. Mater. 2018, 347, 89–94. [Google Scholar] [CrossRef]
- Huang, J.; Cheng, Y.; Wu, Y.; Shi, X.; Du, Y.; Deng, H. Chitosan/tannic acid bilayers layer-by-layer deposited cellulose nanofibrous mats for antibacterial application. Int. J. Biol. Macromol. 2019, 139, 191–198. [Google Scholar] [CrossRef]
- Nablo, B.J.; Rothrock, A.R.; Schoenfisch, M.H. Nitric oxide-releasing sol-gels as antibacterial coatings for orthopedic implants. Biomaterials 2005, 26, 917–924. [Google Scholar] [CrossRef] [PubMed]
- Su, Y.; Feng, T.; Feng, W.; Pei, Y.; Li, Z.; Huo, J.; Xie, C.; Qu, X.; Li, P.; Huang, W. Mussel-Inspired, Surface-Attachable Initiator for Grafting of Antimicrobial and Antifouling Hydrogels. Macromol. Rapid Commun. 2019, 40, 1900268. [Google Scholar] [CrossRef] [PubMed]
- Shi, L.; Ding, P.; Wang, Y.; Zhang, Y.; Ossipov, D.; Hilborn, J. Self-Healing Polymeric Hydrogel Formed by Metal–Ligand Coordination Assembly: Design, Fabrication, and Biomedical Applications. Macromol. Rapid Commun. 2019, 40, 1800837. [Google Scholar] [CrossRef] [PubMed]
- Fullenkamp, D.E.; Rivera, J.G.; Gong, Y.-K.; Lau, K.H.A.; He, L.; Varshney, R.; Messersmith, P.B. Mussel-inspired silver-releasing antibacterial hydrogels. Biomaterials 2012, 33, 3783–3791. [Google Scholar] [CrossRef] [PubMed] [Green Version]
- Black, K.C.L.; Liu, Z.; Messersmith, P.B. Catechol Redox Induced Formation of Metal Core−Polymer Shell Nanoparticles. Chem. Mater. 2011, 23, 1130–1135. [Google Scholar] [CrossRef] [Green Version]
- Lee, H.; Dellatore Shara, M.; Miller William, M.; Messersmith Phillip, B. Mussel-Inspired Surface Chemistry for Multifunctional Coatings. Science 2007, 318, 426–430. [Google Scholar] [CrossRef] [Green Version]
- Akemi Ooka, A.; Garrell, R.L. Surface-enhanced Raman spectroscopy of DOPA-containing peptides related to adhesive protein of marine mussel, Mytilus edulis. Biopolymers 2000, 57, 92–102. [Google Scholar] [CrossRef]
- Schlaich, C.; Li, M.; Cheng, C.; Donskyi, I.; Yu, L.; Song, G.; Osorio, E.; Wei, Q.; Haag, R. Mussel-Inspired Polymer-Based Universal Spray Coating for Surface Modification: Fast Fabrication of Antibacterial and Superhydrophobic Surface Coatings. Adv. Mater. Interfaces 2018, 5, 1701254. [Google Scholar] [CrossRef]
- Ryu, J.H.; Hong, S.; Lee, H. Bio-inspired adhesive catechol-conjugated chitosan for biomedical applications: A mini review. Acta Biomater. 2015, 27, 101–115. [Google Scholar] [CrossRef] [PubMed]
- Kim, K.; Ryu, J.H.; Lee, D.Y.; Lee, H. Bio-inspired catechol conjugation converts water-insoluble chitosan into a highly water-soluble, adhesive chitosan derivative for hydrogels and LbL assembly. Biomater. Sci. 2013, 1, 783–790. [Google Scholar] [CrossRef]
- Lee, K.; Oh, M.H.; Lee, M.S.; Nam, Y.S.; Park, T.G.; Jeong, J.H. Stabilized calcium phosphate nano-aggregates using a dopa-chitosan conjugate for gene delivery. Int. J. Pharm. 2013, 445, 196–202. [Google Scholar] [CrossRef] [PubMed]
- Yavvari, P.S.; Srivastava, A. Robust, self-healing hydrogels synthesised from catechol rich polymers. J. Mater. Chem. B 2014, 3, 899–910. [Google Scholar] [CrossRef] [PubMed]
- Oshita, K.; Takayanagi, T.; Oshima, M.; Motomizu, S. Adsorption Properties of Ionic Species on Cross-linked Chitosans Modified with Catechol and Salicylic Acid Moieties. Anal. Sci. 2008, 24, 665–668. [Google Scholar] [CrossRef] [PubMed] [Green Version]
- Liu, J.; Wen, X.-Y.; Lu, J.-F.; Kan, J.; Jin, C.-H. Free radical mediated grafting of chitosan with caffeic and ferulic acids: Structures and antioxidant activity. Int. J. Biol. Macromol. 2014, 65, 97–106. [Google Scholar] [CrossRef]
- Woranuch, S.; Yoksan, R. Preparation, characterization and antioxidant property of water-soluble ferulic acid grafted chitosan. Carbohydr. Polym. 2013, 96, 495–502. [Google Scholar] [CrossRef]
- Aljawish, A.; Chevalot, I.; Piffaut, B.; Rondeau-Mouro, C.; Girardin, M.; Jasniewski, J.; Scher, J.; Muniglia, L. Functionalization of chitosan by laccase-catalyzed oxidation of ferulic acid and ethyl ferulate under heterogeneous reaction conditions. Carbohydr. Polym. 2012, 87, 537–544. [Google Scholar] [CrossRef]
- Badhani, B.; Sharma, N.; Kakkar, R. Gallic acid: A versatile antioxidant with promising therapeutic and industrial applications. RSC Adv. 2015, 5, 27540–27557. [Google Scholar] [CrossRef]
- Ponsonnet, L.; Reybier, K.; Jaffrezic, N.; Comte, V.; Lagneau, C.; Lissac, M.; Martelet, C. Relationship between surface properties (roughness, wettability) of titanium and titanium alloys and cell behaviour. Mater. Sci. Eng. C 2003, 23, 551–560. [Google Scholar] [CrossRef]
- Huang, H.; Yang, X. Synthesis of polysaccharide-stabilized gold and silver nanoparticles: A green method. Carbohydr. Res. 2004, 339, 2627–2631. [Google Scholar] [CrossRef] [PubMed]
- García-Astrain, C.; Chen, C.; Burón, M.; Palomares, T.; Eceiza, A.; Fruk, L.; Corcuera, M.; Gabilondo, N. Biocompatible Hydrogel Nanocomposite with Covalently Embedded Silver Nanoparticles. Biomacromolecules 2015, 16, 1301–1310. [Google Scholar] [CrossRef] [PubMed]

| Alkali Heat Treatment | Dopamine | CMCS-GA-gel | AgNO3 | |
|---|---|---|---|---|
| Ti | ✗ | ✗ | ✗ | ✗ |
| Ti-OH | ✓ | ✗ | ✗ | ✗ |
| Ti-DA | ✓ | ✓ | ✗ | ✗ |
| Ti-gel | ✓ | ✓ | ✓ | ✗ |
| Ti-gel-AgNPs | ✓ | ✓ | ✓ | ✓ |
Publisher’s Note: MDPI stays neutral with regard to jurisdictional claims in published maps and institutional affiliations. |
© 2021 by the authors. Licensee MDPI, Basel, Switzerland. This article is an open access article distributed under the terms and conditions of the Creative Commons Attribution (CC BY) license (https://creativecommons.org/licenses/by/4.0/).
Share and Cite
Ren, Y.; Qin, X.; Barbeck, M.; Hou, Y.; Xu, H.; Liu, L.; Liu, C. Mussel-Inspired Carboxymethyl Chitosan Hydrogel Coating of Titanium Alloy with Antibacterial and Bioactive Properties. Materials 2021, 14, 6901. https://doi.org/10.3390/ma14226901
Ren Y, Qin X, Barbeck M, Hou Y, Xu H, Liu L, Liu C. Mussel-Inspired Carboxymethyl Chitosan Hydrogel Coating of Titanium Alloy with Antibacterial and Bioactive Properties. Materials. 2021; 14(22):6901. https://doi.org/10.3390/ma14226901
Chicago/Turabian StyleRen, Yanru, Xiaoyan Qin, Mike Barbeck, Yi Hou, Haijun Xu, Luo Liu, and Chaoyong Liu. 2021. "Mussel-Inspired Carboxymethyl Chitosan Hydrogel Coating of Titanium Alloy with Antibacterial and Bioactive Properties" Materials 14, no. 22: 6901. https://doi.org/10.3390/ma14226901
APA StyleRen, Y., Qin, X., Barbeck, M., Hou, Y., Xu, H., Liu, L., & Liu, C. (2021). Mussel-Inspired Carboxymethyl Chitosan Hydrogel Coating of Titanium Alloy with Antibacterial and Bioactive Properties. Materials, 14(22), 6901. https://doi.org/10.3390/ma14226901

